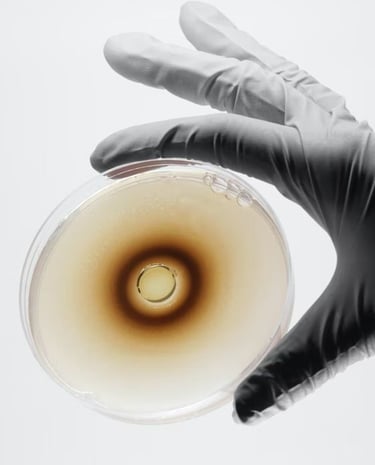

About Gelatin Brodnica
Your Gateway to Poland’s Finest Gelatin As a dedicated partner and authorized distributor for Brodnickie Zakłady Żelatyny (Brodnica Gelatin), we provide streamlined access to the only 100% Polish-owned gelatin production in the world. Brodnica has set the global benchmark for purity; our mission is to deliver that excellence directly to your facility with unmatched reliability.

Our Mission
Uncompromising Quality: Maintaining the highest international standards through rigorous ISO and BRC certifications to ensure our partners receive a product they can trust.
Innovation & Versatility: Continuously evolving our processes to support modern applications, from traditional confectionery and dairy to advanced 3D bioprinting and pharmaceutical delivery systems.
Sustainable Partnerships: Building long-term, transparent relationships with our global clients by providing expert technological consulting and reliable, 100% Polish-owned manufacturing.
Natural Excellence: Honoring the purity of our raw materials to create a biologically inert, highly functional, and versatile product that enhances the health and well-being of consumers on four continents.
Our Gelatin
Quality gelatin sourced from BrodnicaGelatin.








Get in Touch
Questions about our gelatin products? Reach out anytime, we're here to help.
Phone
+1773-559-3284
Neelnanavati23@gmail.com
Stay Updated
Get the latest on our gelatin products
